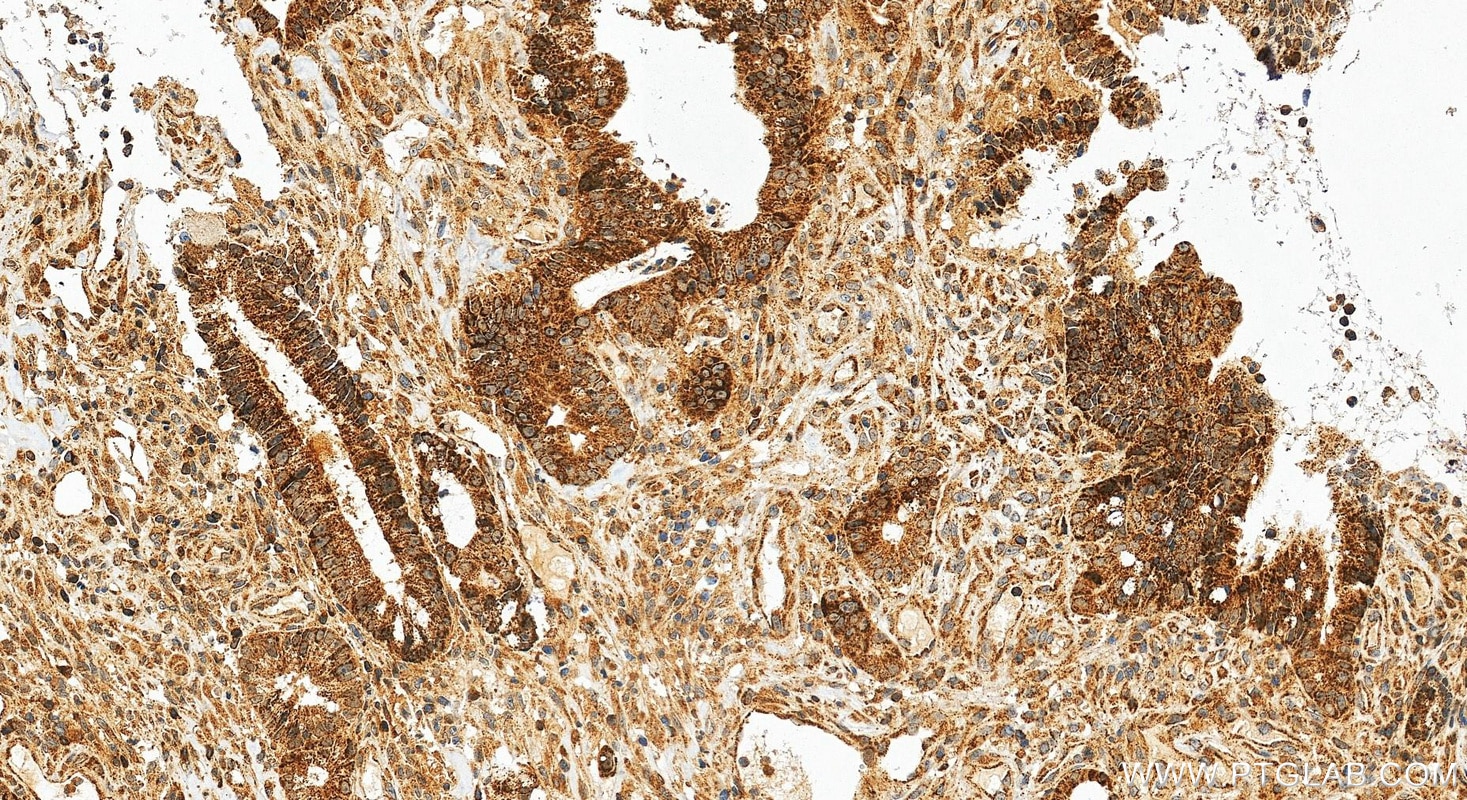
Immunohistochemistry (IHC) staining of human colon cancer tissue using GRSF1 Polyclonal antibody (30992-1-AP)

Tested Applications
| Positive WB detected in | HeLa cells, HepG2 cells, L02 cells, PANC-1 cells |
| Positive IHC detected in | human colon cancer tissue Note: suggested antigen retrieval with TE buffer pH 9.0; (*) Alternatively, antigen retrieval may be performed with citrate buffer pH 6.0 |
| Positive IF/ICC detected in | U-251 cells, A431 cells |
Recommended dilution
| Application | Dilution |
|---|---|
| Western Blot (WB) | WB : 1:5000-1:50000 |
| Immunohistochemistry (IHC) | IHC : 1:500-1:2000 |
| Immunofluorescence (IF)/ICC | IF/ICC : 1:200-1:800 |
| It is recommended that this reagent should be titrated in each testing system to obtain optimal results. | |
| Sample-dependent, Check data in validation data gallery. | |
Product Information
30992-1-AP targets GRSF1 in WB, IHC, IF/ICC, ELISA applications and shows reactivity with human samples.
| Tested Reactivity | human |
| Host / Isotype | Rabbit / IgG |
| Class | Polyclonal |
| Type | Antibody |
| Immunogen |
CatNo: Ag34305 Product name: Recombinant human GRSF1 protein Source: e coli.-derived, PGEX-4T Tag: GST Domain: 282-404 aa of NM_002092 Sequence: MDYRGRRKTGEAYVQFEEPEMANQALLKHREEIGNRYIEIFPSRRNEVRTHVGSYKGKKIASFPTAKYITEPEMVFEEHEVNEDIQPMTAFESEKEIELPKEVPEKLPEAADFGTTSSLHFVH Predict reactive species |
| Full Name | G-rich RNA sequence binding factor 1 |
| Calculated Molecular Weight | 53 kDa |
| Observed Molecular Weight | 50-53 kDa |
| GenBank Accession Number | NM_002092 |
| Gene Symbol | GRSF1 |
| Gene ID (NCBI) | 2926 |
| Conjugate | Unconjugated |
| Form | Liquid |
| Purification Method | Antigen affinity Purification |
| UNIPROT ID | Q12849 |
| Storage Buffer | PBS with 0.02% sodium azide and 50% glycerol, pH 7.3. |
| Storage Conditions | Store at -20°C. Stable for one year after shipment. Aliquoting is unnecessary for -20oC storage. 20ul sizes contain 0.1% BSA. |
Background Information
Grsf1 (G-rich RNA sequence binding factor 1) is an RNA-binding protein, which belongs to the F/H family of heterogeneous ribonucleoprotein, and contains three quasi-RNA recognition motifs (qRRM). These domains enable it to bind to RNA molecules, and it interacts with various RNA molecules, including mRNA, lncRNA and circRNA, affecting the metabolism and function of these RNAs. The expression of GRSF1 is closely related to cell senescence. It was found that with the aging of cells, the methylation level in the promoter region of GRSF1 gene increased, which led to the decrease of its expression. The decrease of GRSF1 expression is related to the activation of various aging-related markers and the increase of the secretion of aging-related secretory phenotype (SASP) factors, which may play a key role in maintaining the normal function of cells and delaying the aging process. GRSF1 also plays an important role in the mitochondria of cells. It interacts with RNase P and participates in the processing of mitochondrial RNA, including the processing of classical and tRNA-free RNA precursors. In the case of GRSF1 deletion, the primary transcript of mitochondrial RNA is cut abnormally, which leads to the decrease of the expression of mitochondrial coding protein, and then causes mitochondrial dysfunction. Isoform 1, 53 kDa, located in mitochondria; Isoform 2, 36 kDa, located in cytoplasm.
Protocols
| Product Specific Protocols | |
|---|---|
| IF protocol for GRSF1 antibody 30992-1-AP | Download protocol |
| IHC protocol for GRSF1 antibody 30992-1-AP | Download protocol |
| WB protocol for GRSF1 antibody 30992-1-AP | Download protocol |
| Standard Protocols | |
|---|---|
| Click here to view our Standard Protocols |